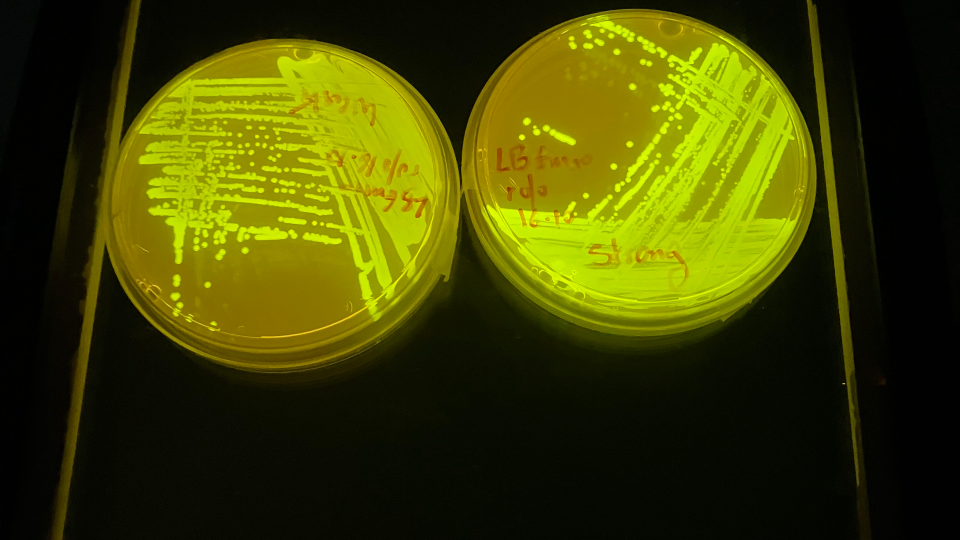
Results

Humans have used cells as tools for thousands of years, starting with fermentation. Current technology enables the precise manipulation of the cell's machinery to perform functions that are too toxic, too small, or too complex for humans or machines to accomplish. The creation of synthetic biological artifacts opens the door to numerous applications that can help achieve sustainable development, such as the real-time detection of heavy metals and toxins in biological systems.
The third edition of the Synthetic Biology Symposium focused on ways to turn whole cells or parts of cells into biosensors, using contaminant detection as a practical model for teaching participants state-of-the-art techniques to construct synthetic biological systems to help in specific tasks relevant to humanity.
We thank Drs. Vanessa Amarelle and Raúl Platero for coordinating the course, held in October at IIBCE, the third edition of their effort to reduce the Latin America and Caribbean region's lag in capacities to develop SynBio solutions.